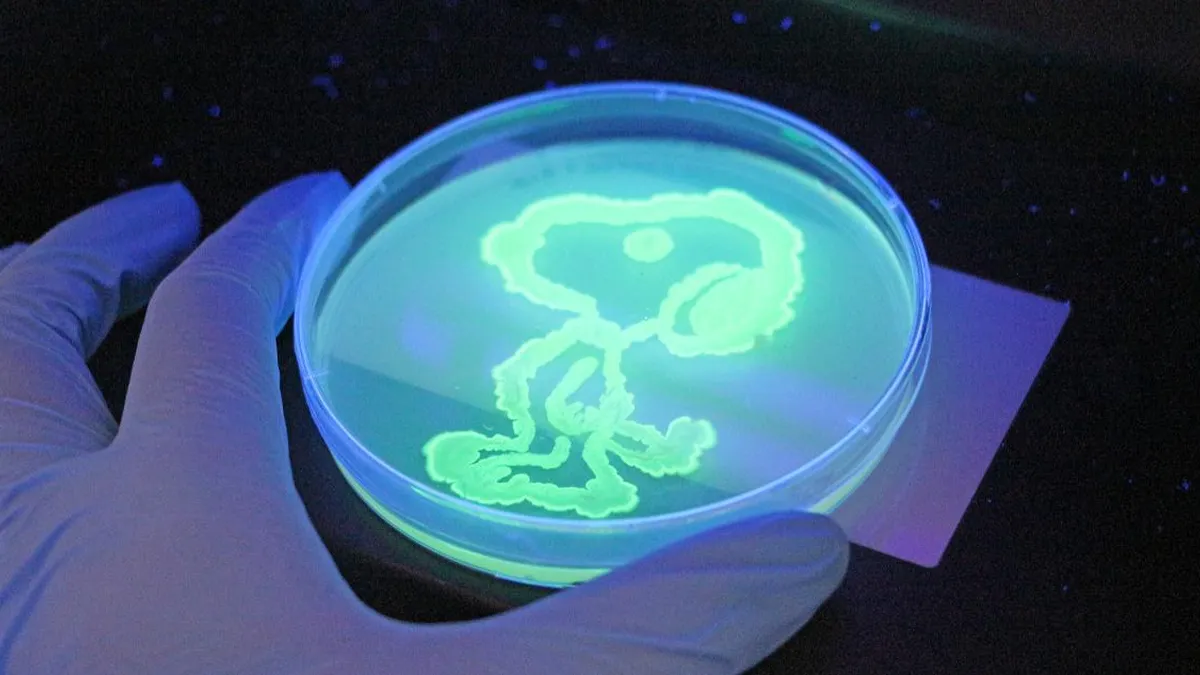
Estudiantes chilenos crean a Estudiantes chilenos crean a

Estudiantes de Ingeniería de la Universidad Católica (UC) han llevado a cabo un innovador experimento que consiste en crear dibujos utilizando la proteína verde fluorescente (GFP) de la medusa Aequorea victoria. Esta proteína, que ha revolucionado el campo de la biología molecular desde su descubrimiento, permite visualizar procesos biológicos en tiempo real, ya que es fluorescente bajo luz azul o ultravioleta y no es tóxica para los organismos.
El uso de la GFP en laboratorios ha sido fundamental para rastrear células y observar procesos en organismos vivos, lo que le valió el Premio Nobel de Química en 2008. En este contexto, los estudiantes de la UC están aprendiendo a aplicar esta tecnología en un entorno práctico.
El experimento se enmarca dentro del Major de Ingeniería Biológica y Biotecnología de la universidad. Según Daniel Garrido, profesor del curso y director de Ingeniería Química y Bioprocesos UC, “usamos la proteína verde fluorescente como una forma visible de enseñar la transformación bacteriana y el trabajo en biotecnología”. Además, Garrido destaca que se buscó dar a los estudiantes la oportunidad de “desarrollar arte con estas bacterias, como si fueran pintura”.
Los alumnos aplicaron en el laboratorio los conceptos teóricos aprendidos, creando dibujos de personajes como Ballerina Capuchina y un Stormtrooper de Star Wars. Para llevar a cabo esta actividad, trabajaron con la bacteria Escherichia coli, la cual fue transformada con un plásmido que permite la expresión de la GFP.
La estudiante Trinidad Peters compartió su experiencia, afirmando que “fue una experiencia muy motivadora aprender lo que está pasando dentro del laboratorio y tener el espacio para jugar, crear y pasarlo bien a través de la ciencia”. Garrido también mencionó que, aunque se trabaja con una biomolécula verde, “este mismo principio se utiliza en aplicaciones reales como la degradación de plásticos, la producción de insulina, anticuerpos o diagnósticos biomédicos”.